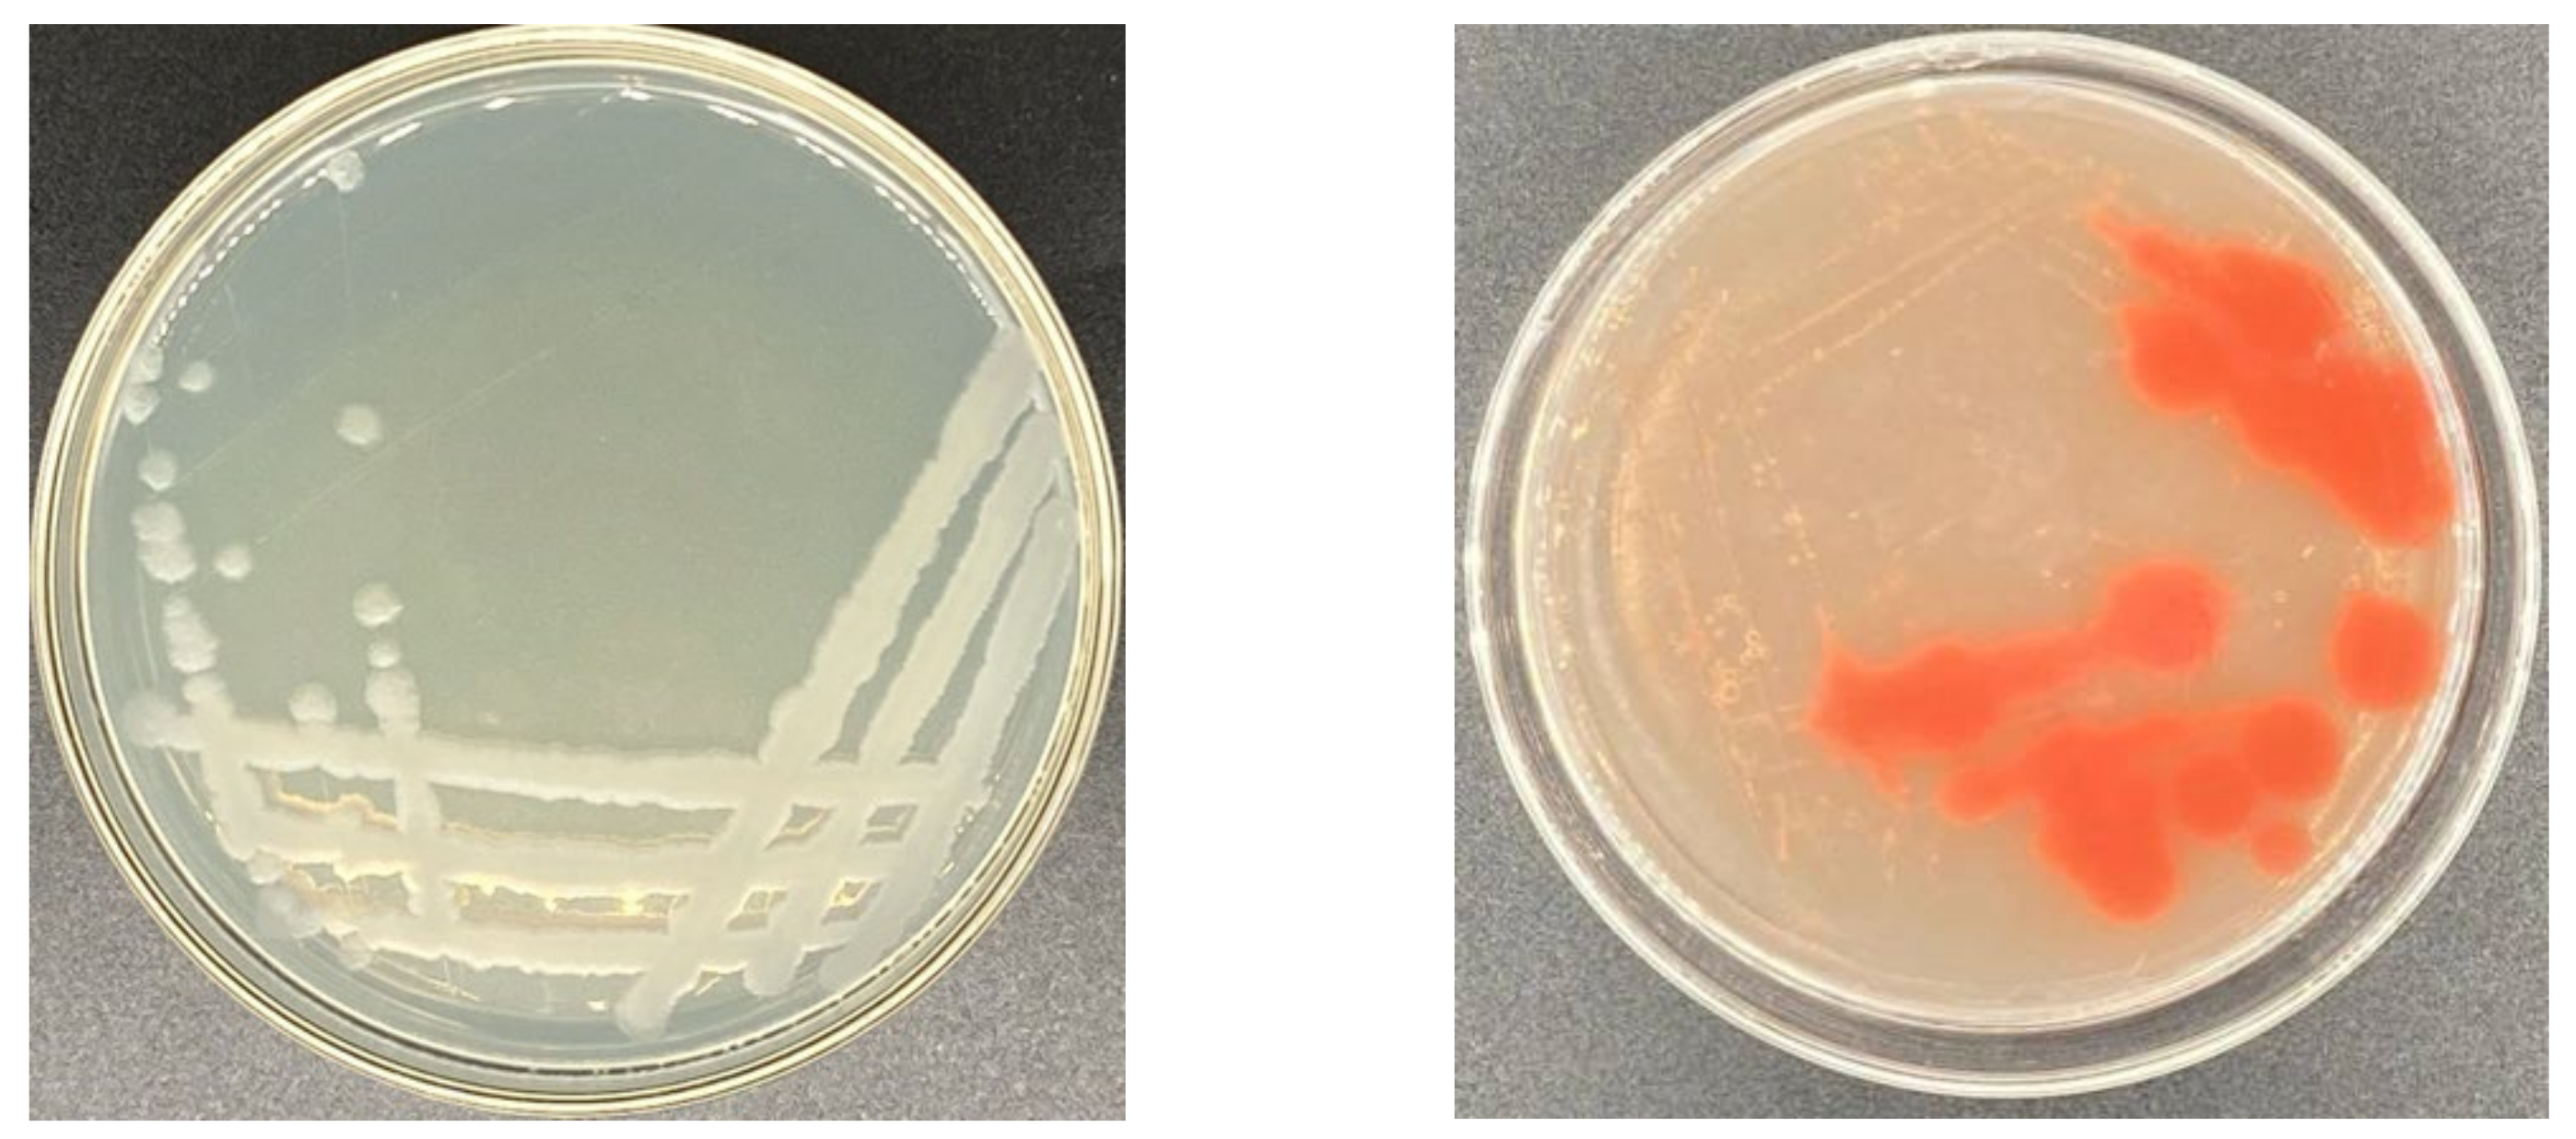

Enhancing the Activity of Carboxymethyl Cellulase Enzyme Using Highly Stable Selenium Nanoparticles Biosynthesized by Bacillus paralicheniformis Y4
Abstract
:1. Introduction
2. Results
2.1. Isolation and Identification of Strains
2.1.1. Determination of Selenium Tolerance of Strains
2.1.2. Identification of Strain Y4
2.2. Bacterial Growth in the Presence or Absence of Selenite
2.3. Selenite Reduction by B. paralicheniformis Y4
2.4. Characterization of the SeNPs Produced by B. paralicheniformis Y4
2.4.1. SEM Analysis
2.4.2. Fourier Transform Infrared (FTIR) Spectroscopy Analysis
2.5. The Effect of pH on the Stability of SeNPs
2.6. Evaluation of Probiotic Properties of B. paralicheniformis Y4
2.6.1. α-Glucosidase Inhibitory Assay
2.6.2. Antioxidant Evaluation of Ethyl Acetate Extract
2.7. Environmental Adaptability of Strain Y4
2.7.1. Effects of Different Temperatures on Strain Growth
2.7.2. Effects of Different NaCl Concentrations on Strain Growth
2.7.3. Effects of Different pH on Strain Growth
2.8. CMCase Activity Assay Containing Selenite
3. Discussion
4. Materials and Methods
4.1. Supplies and Chemicals
4.2. Isolation of the Strain with High Reduction of Na2SeO3 and CMCase Activity
4.3. Identification of the Strain
4.3.1. Morphological Identification of Strain Y4 Containing Selenite
4.3.2. Taxonomical Analyses of Strain Y4
4.3.3. Physiological and Biochemical Tests of Strain Y4
4.4. Growth of Strain Y4 in the Presence or Absence of Selenite
4.5. Selenite Reduction by Strain Y4
4.6. Characterization of SeNPs Synthesized by Strain Y4
4.6.1. Separation and Purification of SeNPs
4.6.2. Characterization and Morphology of SeNPs
4.6.3. Stability of SeNPs at Different pH
4.7. Assay for the Probiotic Activity of Strain Y4
4.7.1. Extraction of Ethyl Acetate Extract of Strain Y4
4.7.2. α-Glucosidase Inhibitory Assay
4.7.3. Antioxidant Evaluation of Ethyl Acetate Extract
ABTS Scavenging Capacity
DPPH Scavenging Capacity
Hydroxyl Scavenging Capacity
4.8. Determination of Environmental Adaptability of Strain Y4
4.8.1. Effects of Different Temperatures on the Growth of Strain Y4
4.8.2. Effects of Different pH on the Growth of Strain Y4
4.8.3. Effects of Different NaCl Concentrations on the Growth of Strain Y4
4.9. CMCase Activity Assay Containing Selenite
4.10. Statistical Analysis
5. Conclusions
Author Contributions
Funding
Institutional Review Board Statement
Informed Consent Statement
Data Availability Statement
Conflicts of Interest
Sample Availability
References
- Mokale Kognou, A.L.; Chio, C.; Khatiwada, J.R.; Shrestha, S.; Chen, X.; Han, S.; Li, H.; Jiang, Z.H.; Xu, C.C.; Qin, W. Characterization of Cellulose-Degrading Bacteria Isolated from Soil and the Optimization of Their Culture Conditions for Cellulase Production. Appl. Biochem. Biotechnol. 2022. online ahead of print. [Google Scholar] [CrossRef]
- Wang, X.; Tian, L.; Li, Y.; Zhong, C.; Tian, C. Effects of exogenous cellulose-degrading bacteria on humus formation and bacterial community stability during composting. Bioresour. Technol. 2022, 359, 127458. [Google Scholar] [CrossRef]
- Das, T.; Ali, F.; Rahman, M.S. Cellulase activity of a novel bacterial strain Arthrobacter woluwensis TDS9: Its application on bioconversion of paper mill sludge. J. Genet. Eng. Biotechnol. 2022, 20, 87. [Google Scholar] [CrossRef]
- Zhang, R.; Yang, Y.; Min, M.; Li, Y. Effect of dietary supplements on Se bioavailability: A comprehensive in vitro and in vivo study. Ecotoxicol. Environ. Saf. 2022, 231, 113193. [Google Scholar] [CrossRef] [PubMed]
- Wang, N.; Tan, H.Y.; Li, S.; Xu, Y.; Guo, W.; Feng, Y. Supplementation of Micronutrient Selenium in Metabolic Diseases: Its Role as an Antioxidant. Oxid. Med. Cell Longev. 2017, 2017, 7478523. [Google Scholar] [CrossRef] [PubMed]
- Lv, Q.; Liang, X.; Nong, K.; Gong, Z.; Qin, T.; Qin, X.; Wang, D.; Zhu, Y. Advances in Research on the Toxicological Effects of Selenium. Bull. Environ. Contam. Toxicol. 2021, 106, 715–726. [Google Scholar] [CrossRef] [PubMed]
- Eswayah, A.S.; Smith, T.J.; Gardiner, P.H. Microbial Transformations of Selenium Species of Relevance to Bioremediation. Appl. Environ. Microbiol. 2016, 82, 4848–4859. [Google Scholar] [CrossRef] [Green Version]
- Wang, Z.; Huang, W.; Pang, F. Selenium in Soil-Plant-Microbe: A Review. Bull. Environ. Contam. Toxicol. 2022, 108, 167–181. [Google Scholar] [CrossRef]
- Wang, D.; Rensing, C.; Zheng, S. Microbial reduction and resistance to selenium: Mechanisms, applications and prospects. J. Hazard Mater. 2022, 421, 126684. [Google Scholar] [CrossRef]
- Ojeda, J.J.; Merroun, M.L.; Tugarova, A.V.; Lampis, S.; Kamnev, A.A.; Gardiner, P.H.E. Developments in the study and applications of bacterial transformations of selenium species. Crit. Rev. Biotechnol. 2020, 40, 1250–1264. [Google Scholar] [CrossRef]
- Manjunatha, C.; Preran Rao, P.; Bhardwaj, P.; Raju, H.; Ranganath, D. New insight into the synthesis, morphological architectures and biomedical applications of elemental selenium nanostructures. Biomed. Mater. 2021, 16, 022010. [Google Scholar]
- Abou Elmaaty, T.; Sayed-Ahmed, K.; Mohamed Ali, R.; El-Khodary, K.; Abdeldayem, S.A. Simultaneous Sonochemical Coloration and Antibacterial Functionalization of Leather with Selenium Nanoparticles (SeNPs). Polymers 2021, 14, 74. [Google Scholar] [CrossRef]
- Jia, X.; Liu, Q.; Zou, S.; Xu, X.; Zhang, L. Construction of selenium nanoparticles/β-glucan composites for enhancement of the antitumor activity. Carbohydr. Polym. 2015, 117, 434–442. [Google Scholar] [CrossRef]
- Truong, L.B.; Medina-Cruz, D.; Mostafavi, E.; Rabiee, N. Selenium Nanomaterials to Combat Antimicrobial Resistance. Molecules 2021, 26, 3611. [Google Scholar] [CrossRef]
- Wu, Z.; Ren, Y.; Liang, Y.; Huang, L.; Yang, Y.; Zafar, A.; Hasan, M.; Yang, F.; Shu, X. Synthesis, Characterization, Immune Regulation, and Antioxidative Assessment of Yeast-Derived Selenium Nanoparticles in Cyclophosphamide-Induced Rats. ACS Omega 2021, 6, 24585–24594. [Google Scholar] [CrossRef]
- Moreno-Martin, G.; Pescuma, M.; Pérez-Corona, T.; Mozzi, F.; Madrid, Y. Determination of size and mass-and number-based concentration of biogenic SeNPs synthesized by lactic acid bacteria by using a multimethod approach. Anal. Chim. Acta 2017, 992, 34–41. [Google Scholar] [CrossRef]
- Mosallam, F.M.; El-Sayyad, G.S.; Fathy, R.M.; El-Batal, A.I. Biomolecules-mediated synthesis of selenium nanoparticles using Aspergillus oryzae fermented Lupin extract and gamma radiation for hindering the growth of some multidrug-resistant bacteria and pathogenic fungi. Microb. Pathog. 2018, 122, 108–116. [Google Scholar] [CrossRef]
- Yang, J.; Yang, H. Recent development in Se-enriched yeast, lactic acid bacteria and bifidobacteria. Crit. Rev. Food Sci. Nutr. 2021, 19, 1–15. [Google Scholar] [CrossRef]
- Gao, X.; Li, X.; Mu, J.; Ho, C.T.; Su, J.; Zhang, Y.; Lin, X.; Chen, Z.; Li, B.; Xie, Y. Preparation, physicochemical characterization, and anti-proliferation of selenium nanoparticles stabilized by Polyporus umbellatus polysaccharide. Int. J. Biol. Macromol. 2020, 152, 605–615. [Google Scholar] [CrossRef]
- Akçay, F.A.; Avcı, A. Effects of process conditions and yeast extract on the synthesis of selenium nanoparticles by a novel indigenous isolate Bacillus sp. EKT1 and characterization of nanoparticles. Arch. Microbiol. 2020, 202, 2233–2243. [Google Scholar] [CrossRef]
- El-Saadony, M.T.; Saad, A.M.; Taha, T.F.; Najjar, A.A.; Zabermawi, N.M.; Nader, M.M.; Abuqamar, S.F.; El-Tarabily, K.A.; Salama, A. Selenium nanoparticles from Lactobacillus paracasei HM1 capable of antagonizing animal pathogenic fungi as a new source from human breast milk. Saudi J. Biol. Sci. 2021, 28, 6782–6794. [Google Scholar] [CrossRef]
- Dwivedi, S.; Alkhedhairy, A.A.; Ahamed, M.; Musarrat, J. Biomimetic synthesis of selenium nanospheres by bacterial strain JS-11 and its role as a biosensor for nanotoxicity assessment: A novel Se-bioassay. PLoS ONE 2013, 8, e57404. [Google Scholar] [CrossRef]
- Krausova, G.; Kana, A.; Vecka, M.; Hyrslova, I.; Stankova, B.; Kantorova, V.; Mrvikova, I.; Huttl, M.; Malinska, H. In Vivo Bioavailability of Selenium in Selenium-Enriched Streptococcus thermophilus and Enterococcus faecium in CD IGS Rats. Antioxidants 2021, 10, 463. [Google Scholar] [CrossRef]
- Angeli, A.; Pinteala, M.; Maier, S.S.; Simionescu, B.C.; Milaneschi, A.; Abbas, G.; Del Prete, S.; Capasso, C.; Capperucci, A.; Tanini, D.; et al. Evaluation of Thio- and Seleno-Acetamides Bearing Benzenesulfonamide as Inhibitor of Carbonic Anhydrases from Different Pathogenic Bacteria. Int. J. Mol. Sci. 2020, 21, 598. [Google Scholar] [CrossRef] [Green Version]
- Xiang, M.; Kang, Q.; Zhang, D. Advances on systems metabolic engineering of Bacillus subtilis as a chassis cell. Synth. Syst. Biotechnol. 2020, 5, 245–251. [Google Scholar] [CrossRef]
- Li, K.; Xu, Q.; Gao, S.; Zhang, S.; Ma, Y.; Zhao, G.; Guo, Y. Highly stable selenium nanoparticles: Assembly and stabilization via flagellin FliC and porin OmpF in Rahnella aquatilis HX2. J. Hazard Mater. 2021, 414, 125545. [Google Scholar] [CrossRef]
- Cai, D.; Rao, Y.; Zhan, Y.; Wang, Q.; Chen, S. Engineering Bacillus for efficient production of heterologous protein: Current progress, challenge and prospect. J. Appl. Microbiol. 2019, 126, 1632–1642. [Google Scholar] [CrossRef] [Green Version]
- Stern, J.; Kahn, A.; Vazana, Y.; Shamshoum, M.; Moraïs, S.; Lamed, R.; Bayer, E.A. Significance of relative position of cellulases in designer cellulosomes for optimized cellulolysis. PLoS ONE 2015, 10, e0127326. [Google Scholar]
- Prasanna, R.; Nain, L.; Tripathi, R.; Gupta, V.; Chaudhary, V.; Middha, S.; Joshi, M.; Ancha, R.; Kaushik, B.D. Evaluation of fungicidal activity of extracellular filtrates of cyanobacteria--possible role of hydrolytic enzymes. J. Basic Microbiol. 2008, 48, 186–194. [Google Scholar] [CrossRef]
- Kang, D.U.; Lee, Y.S.; Lee, J.W. Construction of Escherichia coli BL21/A-53 producing histidine-tagged carboxymethylcellulase and comparison of its characteristics with CMCase without histidine-tag. Prep. Biochem. Biotechnol. 2019, 49, 167–175. [Google Scholar] [CrossRef]
- Chen, X.; Li, S.; Cong, X.; Yu, T.; Zhu, Z.; Barba, F.J.; Marszalek, K.; Puchalski, C.; Cheng, S. Optimization of Bacillus cereus Fermentation Process for Selenium Enrichment as Organic Selenium Source. Front. Nutr. 2020, 7, 543873. [Google Scholar] [CrossRef] [PubMed]
- Hu, Z.; Cheng, Y.; Suzuki, N.; Guo, X.; Xiong, H.; Ogra, Y. Speciation of Selenium in Brown Rice Fertilized with Selenite and Effects of Selenium Fertilization on Rice Proteins. Int. J. Mol. Sci. 2018, 19, 3494. [Google Scholar] [CrossRef] [PubMed] [Green Version]
- Tran, T.a.T.; Zhou, F.; Yang, W.; Wang, M.; Dinh, Q.T.; Wang, D.; Liang, D. Detoxification of mercury in soil by selenite and related mechanisms. Ecotoxicol. Environ. Saf. 2018, 159, 77–84. [Google Scholar] [CrossRef] [PubMed]
- Yu, X.Z.; Gu, J.D. Metabolic responses of weeping willows to selenate and selenite. Environ. Sci. Pollut. Res. Int. 2007, 14, 510–517. [Google Scholar] [CrossRef]
- Dhanjal, S.; Cameotra, S.S. Aerobic biogenesis of selenium nanospheres by Bacillus cereus isolated from coalmine soil. Microb. Cell Fact. 2010, 9, 52. [Google Scholar] [CrossRef] [Green Version]
- Bao, P.; Xiao, K.Q.; Wang, H.J.; Xu, H.; Xu, P.P.; Jia, Y.; Häggblom, M.M.; Zhu, Y.G. Characterization and Potential Applications of a Selenium Nanoparticle Producing and Nitrate Reducing Bacterium Bacillus oryziterrae sp. nov. Sci. Rep. 2016, 6, 34054. [Google Scholar] [CrossRef] [Green Version]
- Khoei, N.S.; Lampis, S.; Zonaro, E.; Yrjälä, K.; Bernardi, P.; Vallini, G. Insights into selenite reduction and biogenesis of elemental selenium nanoparticles by two environmental isolates of Burkholderia fungorum. New Biotechnol. 2017, 34, 1–11. [Google Scholar] [CrossRef]
- Selvaraj, V.; Tomblin, J.; Yeager Armistead, M.; Murray, E. Selenium (sodium selenite) causes cytotoxicity and apoptotic mediated cell death in PLHC-1 fish cell line through DNA and mitochondrial membrane potential damage. Ecotoxicol. Environ. Saf. 2013, 87, 80–88. [Google Scholar] [CrossRef]
- Zhu, Y.; Ren, B.; Li, H.; Lin, Z.; Bañuelos, G.; Li, L.; Zhao, G.; Guo, Y. Biosynthesis of selenium nanoparticles and effects of selenite, selenate, and selenomethionine on cell growth and morphology in Rahnella aquatilis HX2. Appl. Microbiol. Biotechnol. 2018, 102, 6191–6205. [Google Scholar] [CrossRef]
- Wang, Y.; Shu, X.; Zhou, Q.; Fan, T.; Wang, T.; Chen, X.; Li, M.; Ma, Y.; Ni, J.; Hou, J.; et al. Selenite Reduction and the Biogenesis of Selenium Nanoparticles by Alcaligenes faecalis Se03 Isolated from the Gut of Monochamus alternatus (Coleoptera: Cerambycidae). Int. J. Mol. Sci. 2018, 19, 2799, Correction in Int. J. Mol. Sci. 2020, 21, 1294. [Google Scholar] [CrossRef] [Green Version]
- Kamnev, A.A.; Dyatlova, Y.A.; Kenzhegulov, O.A.; Vladimirova, A.A.; Mamchenkova, P.V.; Tugarova, A.V. Fourier Transform Infrared (FTIR) Spectroscopic Analyses of Microbiological Samples and Biogenic Selenium Nanoparticles of Microbial Origin: Sample Preparation Effects. Molecules 2021, 26, 1146. [Google Scholar] [CrossRef]
- Wang, Y.; Ye, Q.; Sun, Y.; Jiang, Y.; Meng, B.; Du, J.; Chen, J.; Tugarova, A.V.; Kamnev, A.A.; Huang, S. Selenite Reduction by Proteus sp. YS02: New Insights Revealed by Comparative Transcriptomics and Antibacterial Effectiveness of the Biogenic Se(0) Nanoparticles. Front. Microbiol. 2022, 13, 845321. [Google Scholar] [CrossRef]
- Leclercq-Perlat, M.N.; Sicard, M.; Trelea, I.C.; Picque, D.; Corrieu, G. Temperature and relative humidity influence the microbial and physicochemical characteristics of Camembert-type cheese ripening. J. Dairy Sci. 2012, 95, 4666–4682. [Google Scholar] [CrossRef] [Green Version]
- Zi, Z.D.; Wen, W.; Ma, F.; Li, W.; Wang, Z.X.; Lu, J.; Lv, J. Microvirga puerhi sp. nov., isolated from Puerh tea garden soil. Arch. Microbiol. 2022, 204, 390. [Google Scholar] [CrossRef]
- Gao, Z.Y.; Xue, H.P.; Wang, L.; Yao, Y.; Zhang, D.F.; Huang, J.; Liu, C.; Zhang, A.H. Sphingopyxis jiangsuensis sp. nov. Isolated From the Surface Water of the Yellow Sea. Curr. Microbiol. 2022, 79, 214. [Google Scholar] [CrossRef]
- Burel, C.; Kala, A.; Purevdorj-Gage, L. Impact of pH on citric acid antimicrobial activity against Gram-negative bacteria. Lett. Appl. Microbiol. 2021, 72, 332–340. [Google Scholar] [CrossRef]
- Lampis, S.Z.; Bertolini, E.C.; Bernardi, P.; Butler, C.S.; Vallini, G. Delayed formation of zero-valent selenium nanoparticles by Bacillus mycoides SeITE01 as a consequence of selenite reduction under aerobic conditions. Microb. Cell Fact. 2014, 13, 35. [Google Scholar] [CrossRef] [Green Version]
- Ashengroph, M.; Hosseini, S.R. A newly isolated Bacillus amyloliquefaciens SRB04 for the synthesis of selenium nanoparticles with potential antibacterial properties. Int. Microbiol. 2021, 24, 103–114. [Google Scholar] [CrossRef]
- Ullah, A.; Yin, X.; Wang, F.; Xu, B.; Mirani, Z.A.; Xu, B.; Chan, M.W.H.; Ali, A.; Usman, M.; Ali, N.; et al. Biosynthesis of Selenium Nanoparticles (via Bacillus subtilis BSN313), and Their Isolation, Characterization, and Bioactivities. Molecules 2021, 26, 5559. [Google Scholar] [CrossRef]
- Borah, S.N.; Goswami, L.; Sen, S.; Sachan, D.; Sarma, H.; Montes, M.; Peralta-Videa, J.R.; Pakshirajan, K.; Narayan, M. Selenite bioreduction and biosynthesis of selenium nanoparticles by Bacillus paramycoides SP3 isolated from coal mine overburden leachate. Environ. Pollut. 2021, 285, 117519. [Google Scholar] [CrossRef]
- Wang, Y.; Shu, X.; Hou, J.; Lu, W.; Zhao, W.; Huang, S.; Wu, L. Selenium Nanoparticle Synthesized by Proteus mirabilis YC801: An Efficacious Pathway for Selenite Biotransformation and Detoxification. Int. J. Mol. Sci. 2018, 19, 3809. [Google Scholar] [CrossRef] [Green Version]
- Hsieh, H.S.; Ganther, H.E. Acid-volatile selenium formation catalyzed by glutathione reductase. Biochemistry 1975, 14, 1632–1636. [Google Scholar] [CrossRef]
- Wang, T.; Yang, L.; Zhang, B.; Liu, J. Extracellular biosynthesis and transformation of selenium nanoparticles and application in H2O2 biosensor. Colloids Surf. B Biointerfaces 2010, 80, 94–102. [Google Scholar] [CrossRef]
- Forootanfar, H.; Adeli-Sardou, M.; Nikkhoo, M.; Mehrabani, M.; Amir-Heidari, B.; Shahverdi, A.R.; Shakibaie, M. Antioxidant and cytotoxic effect of biologically synthesized selenium nanoparticles in comparison to selenium dioxide. J. Trace Elem. Med. Biol. 2014, 28, 75–79. [Google Scholar] [CrossRef]
- Lampis, S.; Zonaro, E.; Bertolini, C.; Cecconi, D.; Monti, F.; Micaroni, M.; Turner, R.J.; Butler, C.S.; Vallini, G. Selenite biotransformation and detoxification by Stenotrophomonas maltophilia SeITE02: Novel clues on the route to bacterial biogenesis of selenium nanoparticles. J Hazard Mater. 2017, 324 Pt A, 3–14. [Google Scholar] [CrossRef]
- Debieux, C.M.; Dridge, E.J.; Mueller, C.M.; Splatt, P.; Paszkiewicz, K.; Knight, I.; Florance, H.; Love, J.; Titball, R.W.; Lewis, R.J.; et al. A bacterial process for selenium nanosphere assembly. Proc. Natl. Acad. Sci. USA 2011, 108, 13480–13485. [Google Scholar] [CrossRef] [Green Version]
- Abdelsamad, N.O.; Esawy, M.A.; Mahmoud, Z.E.; El-Shazly, A.I.; Elsayed, T.R.; Gamal, A.A. Evaluation of different bacterial honey isolates as probiotics and their efficient roles in cholesterol reduction. World J. Microbiol. Biotechnol. 2022, 38, 106. [Google Scholar] [CrossRef]
- Chen, H.; Du, G.; Yan, X.; Ye, H.; Guo, Q.; Wang, Z.; Yuan, Y.; Yue, T. Selenium-Enriched Pediococcus acidilactici MRS-7 Alleviates Patulin-Induced Jejunum Injuries in Mice and Its Possible Mechanisms. J. Agric. Food Chem. 2022, 70, 4755–4764. [Google Scholar] [CrossRef]
- Anu; Kumar, S.; Kumar, A.; Kumar, V.; Singh, B. Optimization of cellulase production by Bacillus subtilis subsp. subtilis JJBS300 and biocatalytic potential in saccharification of alkaline-pretreated rice straw. Prep. Biochem. Biotechnol. 2021, 51, 697–704. [Google Scholar] [CrossRef]
- Beukes, N.; Pletschke, B.I. Effect of sulfur-containing compounds on Bacillus cellulosome-associated ‘CMCase’ and ‘Avicelase’ activities. FEMS Microbiol. Lett. 2006, 264, 226–231. [Google Scholar] [CrossRef] [Green Version]
- Da Silva, R.N.; Melo, L.F.A.; Luna Finkler, C.L. Optimization of the cultivation conditions of Bacillus licheniformis BCLLNF-01 for cellulase production. Biotechnol. Rep. 2021, 29, e00599. [Google Scholar] [CrossRef] [PubMed]
- Sreena, C.P.; Sebastian, D. Augmented cellulase production by Bacillus subtilis strain MU S1 using different statistical experimental designs. J. Genet. Eng. Biotechnol. 2018, 16, 9–16. [Google Scholar] [CrossRef] [PubMed]
- Kato, S.; Haruta, S.; Cui, Z.J.; Ishii, M.; Igarashi, Y. Effective cellulose degradation by a mixed-culture system composed of a cellulolytic Clostridium and aerobic non-cellulolytic bacteria. FEMS Microbiol. Ecol. 2004, 51, 133–142. [Google Scholar] [CrossRef] [PubMed] [Green Version]
- Guo, Z.; Zhu, B.; Guo, J.; Wang, G.; Li, M.; Yang, Q.; Wang, L.; Fei, Y.; Wang, S.; Yu, T.; et al. Impact of selenium on rhizosphere microbiome of a hyperaccumulation plant Cardamine violifolia. Environ. Sci. Pollut. Res. Int. 2022, 29, 40241–40251. [Google Scholar] [CrossRef]
- Kwoji, I.D.; Okpeku, M.; Adeleke, M.A.; Aiyegoro, O.A. Formulation of Chemically Defined Media and Growth Evaluation of Ligilactobacillus salivarius ZJ614 and Limosilactobacillus reuteri ZJ625. Front. Microbiol. 2022, 13, 1450. [Google Scholar] [CrossRef]
- Rao, S.; Yu, T.; Cong, X.; Xu, F.; Lai, X.; Zhang, W.; Liao, Y.; Cheng, S. Integration analysis of PacBio SMRT- and Illumina RNA-seq reveals candidate genes and pathway involved in selenium metabolism in hyperaccumulator Cardamine violifolia. BMC Plant Biol. 2020, 20, 492. [Google Scholar] [CrossRef]
- Rajan, B.M.; Kannabiran, K. Extraction and Identification of Antibacterial Secondary Metabolites from Marine Streptomyces sp. VITBRK2. Int. J. Mol. Cell Med. 2014, 3, 130–137. [Google Scholar]
- Marounek, M.; Fliegrova, K.; Bartos, S. Metabolism and some characteristics of ruminal strains of Megasphaera elsdenii. Appl. Environ. Microbiol. 1989, 55, 1570–1573. [Google Scholar] [CrossRef] [Green Version]
- Yoon, S.H.; Ha, S.M.; Kwon, S.; Lim, J.; Kim, Y.; Seo, H.; Chun, J. Introducing EzBioCloud: A taxonomically united database of 16S rRNA gene sequences and whole-genome assemblies. Int. J. Syst. Evol. Microbiol. 2017, 67, 1613–1617. [Google Scholar] [CrossRef]
- Baggio, G.; Groves, R.A.; Chignola, R.; Piacenza, E.; Presentato, A.; Lewis, I.A.; Lampis, S.; Vallini, G.; Turner, R.J. Untargeted Metabolomics Investigation on Selenite Reduction to Elemental Selenium by Bacillus mycoides SeITE01. Front. Microbiol. 2021, 12, 2574. [Google Scholar] [CrossRef]
- Ridley, H.; Watts, C.A.; Richardson, D.J.; Butler, C.S. Resolution of distinct membrane-bound enzymes from Enterobacter cloacae SLD1a-1 that are responsible for selective reduction of nitrate and selenate oxyanions. Appl. Environ. Microbiol. 2006, 72, 5173–5180. [Google Scholar] [CrossRef] [Green Version]
- Larsen, E.H.; Lobinski, R.; Burger-Meÿer, K.; Hansen, M.; Ruzik, R.; Mazurowska, L.; Rasmussen, P.H.; Sloth, J.J.; Scholten, O.; Kik, C. Uptake and speciation of selenium in garlic cultivated in soil amended with symbiotic fungi (mycorrhiza) and selenate. Anal. Bioanal. Chem. 2006, 385, 1098–1108. [Google Scholar] [CrossRef]
- Baldwin, A.D.; Kiick, K.L. Polysaccharide-modified synthetic polymeric biomaterials. Biopolymers 2010, 94, 128–140. [Google Scholar] [CrossRef] [Green Version]
- Ukwatta, K.M.; Lawrence, J.L.; Wijayarathna, C.D. The study of antimicrobial, anti-cancer, anti-inflammatory and α-glucosidase inhibitory activities of Nigronapthaphenyl, isolated from an extract of Nigrospora sphaerica. Mycology 2019, 10, 222–228. [Google Scholar] [CrossRef] [Green Version]
- Ukwatta, K.M.; Lawrence, J.L.; Wijayarathne, C.D. Antimicrobial, anti-cancer, anti-filarial and anti-inflammatory activities of Cowabenzophenone A extracted from the endophytic fungus Aspergillus terreus isolated from a mangrove plant Bruguiera gymnorrhyza. Mycology 2019, 11, 297–305. [Google Scholar] [CrossRef] [Green Version]
- Re, R.; Pellegrini, N.; Proteggente, A.; Pannala, A.; Yang, M.; Rice-Evans, C. Antioxidant activity applying an improved ABTS radical cation decolorization assay. Free Radic. Biol. Med. 1999, 26, 1231–1237. [Google Scholar] [CrossRef]
- Gulcin, I. Antioxidants and antioxidant methods: An updated overview. Arch. Toxicol. 2020, 94, 651–715. [Google Scholar] [CrossRef] [Green Version]
- Brands, S.; Schein, P.; Castro-Ochoa, K.F.; Galinski, E.A. Hydroxyl radical scavenging of the compatible solute ectoine generates two N-acetimides. Arch. Biochem. Biophys. 2019, 674, 108097. [Google Scholar] [CrossRef]
- Bao, P.; Huang, H.; Hu, Z.Y.; Häggblom, M.M.; Zhu, Y.G. Impact of temperature, CO2 fixation and nitrate reduction on selenium reduction, by a paddy soil Clostridium strain. J. Appl. Microbiol. 2013, 114, 703–712. [Google Scholar] [CrossRef]
- Chandran, A.; Pradhan, S.K.; Heinonen-Tanski, H. Survival of enteric bacteria and coliphage MS2 in pure human urine. J. Appl. Microbiol. 2009, 107, 1651–1657. [Google Scholar] [CrossRef]
- Singh, S.; Moholkar, V.S.; Goyal, A. Isolation, Identification, and Characterization of a Cellulolytic Bacillus amyloliquefaciens Strain SS35 from Rhinoceros Dung. ISRN Microbiol. 2013, 2013, 728134. [Google Scholar] [CrossRef] [Green Version]
- Balasubramanian, N.; Toubarro, D.; Teixeira, M.; Simõs, N. Purification and biochemical characterization of a novel thermo-stable carboxymethyl cellulase from Azorean isolate Bacillus mycoides S122C. Appl. Biochem. Biotechnol. 2012, 168, 2191–2204. [Google Scholar] [CrossRef]

| Stain | Selenium Tolerance (mM) | The Ratio of Hydrolysis Circle Diameter (d/D) |
|---|---|---|
| A1 | 200 | 2.75 |
| B17 | 250 | 2.01 |
| C8 | 250 | 2.64 |
| Y4 | 400 | 3.23 |
| SMJ-A8 | 200 | 3.10 |
| SMJ-B9 | 300 | 2.93 |
| SMJ-D11 | 250 | 1.97 |
| SMJ-E13 | 300 | 2.31 |
| SMJ-F20 | 200 | 2.84 |
| XYT-A09 | 350 | 3.12 |
| XYT-B15 | 200 | 3.02 |
| XYT-B17 | 250 | 3.19 |
| XYT-C03 | 300 | 2.93 |
| XYT-D19 | 350 | 2.84 |
| XYT-E12 | 250 | 2.71 |
| XYT-G05 | 200 | 2.56 |
| Characteristic | Strain | |
|---|---|---|
| Strain Y4 | Bacillus licheniformis | |
| Voges-Proskauer test | + | + |
| L-arabinose | − | − |
| D-mannose | + | + |
| Sucrose | − | − |
| α-D-glucose | + | + |
| Lactose | − | − |
| Item | The Concentration of Ethyl Acetate Extract (μg/mL) | The Free Radical Scavenging Rate (%) |
|---|---|---|
| ABTS | 16 | 97.8 ± 0.87 |
| DPPH | 480 | 30.3 ± 2.8 |
| Hydroxyl | 320 | 78.5 ± 2.2 |
Publisher’s Note: MDPI stays neutral with regard to jurisdictional claims in published maps and institutional affiliations. |
© 2022 by the authors. Licensee MDPI, Basel, Switzerland. This article is an open access article distributed under the terms and conditions of the Creative Commons Attribution (CC BY) license (https://creativecommons.org/licenses/by/4.0/).
Share and Cite
Wang, Y.; Yu, Y.; Duan, Y.; Wang, Q.; Cong, X.; He, Y.; Gao, C.; Hafeez, M.; Jan, S.; Rasheed, S.M.; et al. Enhancing the Activity of Carboxymethyl Cellulase Enzyme Using Highly Stable Selenium Nanoparticles Biosynthesized by Bacillus paralicheniformis Y4. Molecules 2022, 27, 4585. https://doi.org/10.3390/molecules27144585
Wang Y, Yu Y, Duan Y, Wang Q, Cong X, He Y, Gao C, Hafeez M, Jan S, Rasheed SM, et al. Enhancing the Activity of Carboxymethyl Cellulase Enzyme Using Highly Stable Selenium Nanoparticles Biosynthesized by Bacillus paralicheniformis Y4. Molecules. 2022; 27(14):4585. https://doi.org/10.3390/molecules27144585
Chicago/Turabian StyleWang, Yidan, Yonghe Yu, Yuhua Duan, Qin Wang, Xin Cong, Yi He, Chao Gao, Muhammad Hafeez, Saad Jan, Syed Majid Rasheed, and et al. 2022. "Enhancing the Activity of Carboxymethyl Cellulase Enzyme Using Highly Stable Selenium Nanoparticles Biosynthesized by Bacillus paralicheniformis Y4" Molecules 27, no. 14: 4585. https://doi.org/10.3390/molecules27144585
APA StyleWang, Y., Yu, Y., Duan, Y., Wang, Q., Cong, X., He, Y., Gao, C., Hafeez, M., Jan, S., Rasheed, S. M., Cheng, S., & Wang, Z. (2022). Enhancing the Activity of Carboxymethyl Cellulase Enzyme Using Highly Stable Selenium Nanoparticles Biosynthesized by Bacillus paralicheniformis Y4. Molecules, 27(14), 4585. https://doi.org/10.3390/molecules27144585






